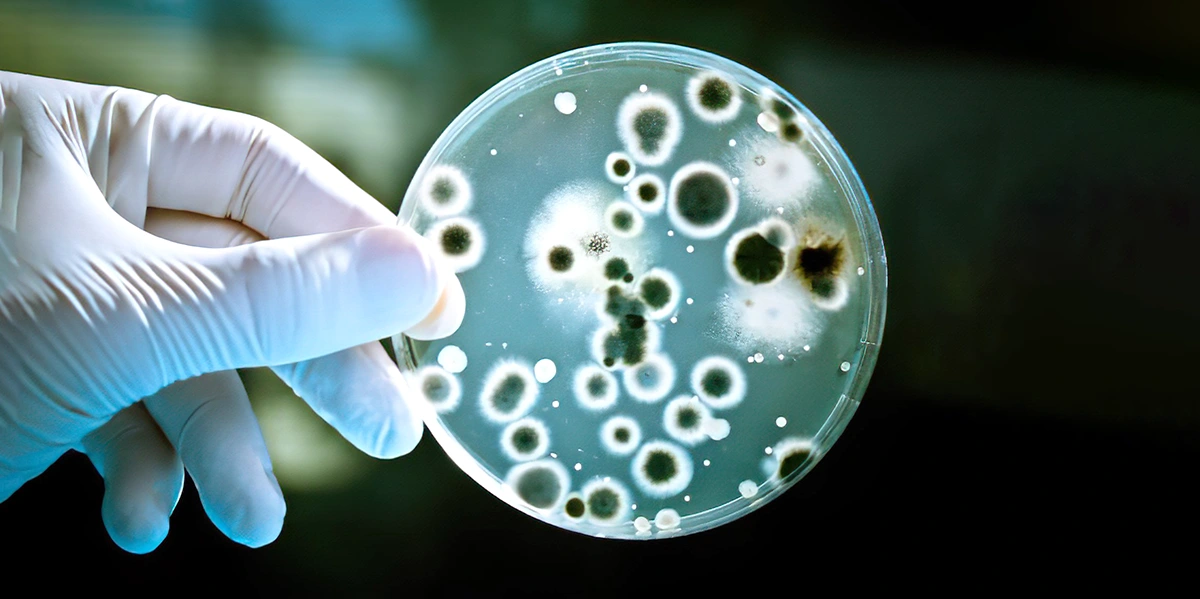

Ölümcül Süper Mikroplara Karşı 100 Kat Daha Güçlü Yeni Bir Antibiyotik Keşfedildi
Warwick ve Monash Üniversitelerinden bilim insanları, MRSA ve VRE gibi ölümcül süper mikroplara karşı mevcut ilaçlardan 100 kat daha güçlü yeni bir antibiyotik keşfetti. Streptomyces coelicolor bakterisinde bulunan pre-metilenomisin C lakton isimli bileşik, laboratuvar testlerinde dirençli süper mikroplara oldukça başarılı sonuçlar sağladı. Uzmanlar bu önemli keşfin antibiyotik direncine karşı mücadelede yeni bir dönemin başlangıcı olarak görülüyor.
50 Yıllık Bilinmezlik: “Göz Önünde Saklanan” Bir Molekül
Journal of the American Chemical Society dergisinde yayımlanan araştırmaya göre, metilenomisin A antibiyotiğinin doğal üretim süreci sırasında ortaya çıkan ara bir bileşiğin, yani pre-metilenomisin C laktonun, olağanüstü güçlü bir antibakteriyel etkiye sahip olduğunu belirlendi.
Clovibactin: Dirençli mikroplara karşı çok güçlü yeni bir antibiyotik keşfedildi
Çalışmanın yazarlarından Monash Üniversitesi Biyomedikal Keşif Enstitüsü’nden Prof. Greg Challis, araştırmaları ile ilgili şu saptamayı yapıyor: “Metilenomisin A yaklaşık 50 yıl önce keşfedilmişti. Ancak bu bileşiğin sentezinde oluşan ara ürünlerin antibakteriyel aktivitesi hiç test edilmemişti. Biz biyosentetik genlerden bazılarını devre dışı bırakarak, metilenomisin A’dan çok daha güçlü iki yeni ara ürün keşfetmiş olduk.”
Mevcut ilaçlardan 100 Kat Daha Güçlü
Testler, bu ara ürünlerden biri olan pre-metilenomisin C laktonun, Gram pozitif bakterilere karşı metilenomisin A’dan 100 kat daha güçlü olduğunu gösterdi. İlacın özellikle Staphylococcus aureus (MRSA) ve Enterococcus faecium (VRE) türlerine karşı son derece etkili olduğu saptandı. Araştırmacılar, bakterinin evrimsel süreçte başlangıçta daha güçlü olan pre-metilenomisin C laktonu üretirken, zamanla daha zayıf bir form olan metilenomisin A’ya yönelmiş olabileceğini düşünüyor.
Warwick Üniversitesi’nden Doç. Lona Alkhalaf, “Bu keşif gerçekten şaşırtıcı. Çünkü bu güçlü antibiyotiği üreten Streptomyces coelicolor bakterisi, 1950’lerden beri antibiyotik araştırmalarında model organizma olarak kullanılıyor. Böylesine iyi bilinen bir mikroorganizmada tamamen yeni bir antibiyotik bulmak beklenmedik bir gelişme” diyor.
Antimikrobiyal direnç giderek artan bir sorun ve toplumsal mücadele gerekli
Direnç Gelişmedi
Daha da önemlisi, ekip Enterococcus suşlarında pre-metilenomisin C laktona karşı hiçbir direnç gelişmediğini bildirdi. Bu testler, genellikle vankomisine karşı direnç gelişimini kolaylaştıran koşullar altında yapıldı. Vankomisin, birçok dirençli enfeksiyonda “son çare” tedavi olarak kullanıldığından, bu sonuç özellikle umut verici kabul ediliyor.
Antibiyotik Keşfinde Yeni Bir Yaklaşım
Bu keşif, antibiyotik araştırmalarında yeni bir paradigmayı işaret ettiğini söyleyen Prof. Challis, “Doğal bileşiklerin üretim yollarında yer alan ara maddeleri tanımlayıp test ederek, direnç geliştirmeye karşı daha dayanıklı yeni bir antibiyotik bulabiliriz,” dedi.
Araştırmacılar şimdi ilacın preklinik testlerine hazırlanıyor. Journal of Organic Chemistry dergisinde yayımlanan bir diğer çalışma, Monash Üniversitesi’nde Prof. David Lupton liderliğindeki ekibin pre-metilenomisin C lakton için ölçeklenebilir bir sentez yöntemi geliştirdiğini bildiriyor. Bu sayede farklı yapısal türevler üretilerek ilacın etki mekanizması daha derinlemesine incelenebilecek. Prof. Lupton, “Bu basit yapıya sahip bileşiğin farklı analoglarını sentezleyerek, hem etkinlik hem de etki mekanizması hakkında önemli bilgiler elde edeceğiz,” dedi.
Yeni Çalışma: Akciğer Hastalıkları Sonrası Gelişen Mantar Enfeksiyonu Ölümcül Olabilir
Antibiyotik Direncine Karşı Yeni Umut
Pre-metilenomisin C lakton; güçlü antibakteriyel etkisi, direnç gelişimine karşı dayanıklılığı ve kolay üretilebilir yapısıyla öne çıkıyor. Uzmanlara göre bu yeni antibiyotik, her yıl yaklaşık 1,1 milyon kişinin ölümüne yol açanantibiyotik direncine karşı mücadelede dönüm noktası olabilir.
Dünya Sağlık Örgütü (DSÖ) antimikrobiyal direnci, küresel sağlık için en önemli tehditlerden biri olarak kabul ediyor. Kurum yakın zamanda, “geliştirilme aşamasında çok az antibakteriyel” olduğu konusunda uyarılar yapmıştı. Yeni antibiyotik geliştirmenin maliyetli olması ve sınırlı finansal getiri sağlaması nedeniyle, çok az ilaç şirketi bu kritik alana yatırım yapmaktadır.
Araştırmanın Özeti
Metilenomisin Biyosentezinde İlaç Dirençli Gram-pozitif Bakterilere Karşı Etkili Yeni Ara Ürünlerin Keşfi
Özet: Metilenomisinler, Streptomyces coelicolor A3(2) bakterisi tarafından üretilen, yüksek oranda fonksiyonelleştirilmiş siklopentanon yapısında antibiyotiklerdir. Metilenomisinlerin biyosentetik yolu, ilgili gen kümesindeki proteinlerin dizilim analizine ve işaretli öncüllerin dâhil edilmesine dayanarak daha önce öne sürülmüştür. Ancak bu biyosentetik enzimlerin varsayılan rolleri şimdiye kadar deneysel olarak araştırılmamıştı. Bu çalışmada, mmyD, mmyO, mmyF ve mmyE genlerinin her birinde çerçeve içi delesyonlar oluşturularak, bu genlerin kodladığı enzimlerin metilenomisin üretimindeki biyosentetik işlevleri incelendi. mmyD geninde mutasyon yapılan bakteriler, hiçbir metilenomisinle ilişkili metabolit üretmedi; bu da MmyD enziminin erken bir biyosentetik adımda görev aldığına dair varsayımı destekledi.
Antibiyotik direncini önlemek için tedaviye bilimsel veri sağlanarak çözüm aranmalı
mmyF ve mmyO genlerinde mutasyon yapılan suşlarda metilenomisin A üretimi tamamen dururken, metilenomisin C üretimi devam etti. Bu durum, söz konusu enzimlerin metilenomisin C’nin epoksidasyonunu katalize ettiğine dair önceki varsayımı doğruladı. Metilenomisin direnci sağlayan mmr genini taşıyan, genetiği değiştirilmiş bir S. coelicolor M145türevinde mmyF ve mmyO genlerinin eksprese edilmesi, bakterinin metilenomisin C’yi metilenomisin A’ya dönüştürmesini sağladı ve hipotezi teyit etti. mmyE geninde mutasyon yapılan suşlarda ise “pre-metilenomisin C” adlı yeni bir metabolit birikti. Bu bileşik kolayca siklizasyona uğrayarak “pre-metilenomisin C lakton” adlı butanol türevine dönüştü. Bu bulgu, ilgili enzimin metilenomisin C yapısına ekso-metilen grubunu eklemekten sorumlu olduğunu gösterdi.
Dikkat çekici şekilde, hem pre-metilenomisin C hem de lakton öncülü, antibiyotik dirençli Staphylococcus aureus ve Enterococcus faecium izolatları da dâhil olmak üzere çeşitli Gram-pozitif bakterilere karşı metilenomisin A ve C’den 10 ila 100 kat daha güçlü antibakteriyel etki gösterdi. Bu sonuç, antimikrobiyal dirençle mücadelede kullanılabilecek yeni antibiyotiklerin geliştirilmesi için umut verici bir başlangıç noktası sunuyor.
Kaynaklar ve Referanslar:
1- Discovery of Late Intermediates in Methylenomycin Biosynthesis Active against Drug-Resistant Gram-Positive Bacterial Pathogens2- New antibiotic for drug-resistant bacteria found hiding in plain sightYAZIYI PAYLAŞ



 Çocuklarda antibiyotik kullanımı, ailenin bilgi ve tutumu
Çocuklarda antibiyotik kullanımı, ailenin bilgi ve tutumu Antibiyotik nedir, nasıl kullanılır? Faydaları, direnci ve zararları
Antibiyotik nedir, nasıl kullanılır? Faydaları, direnci ve zararları Clovibactin: Dirençli mikroplara karşı çok güçlü yeni bir antibiyotik keşfedildi
Clovibactin: Dirençli mikroplara karşı çok güçlü yeni bir antibiyotik keşfedildi Çocuk gelişimi ve psikolojisi: Gelişimini etkileyen faktörler
Çocuk gelişimi ve psikolojisi: Gelişimini etkileyen faktörler Genetik Hastalıklar: Osteogenezis imperfekta (OI) nedenleri, belirtileri ve tedavisi
Genetik Hastalıklar: Osteogenezis imperfekta (OI) nedenleri, belirtileri ve tedavisi
YORUMUNUZ VAR MI?